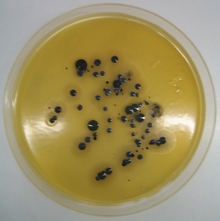

Nährmedium

Ein Nährmedium, auch als Kulturmedium bezeichnet, dient zur Kultivierung von Mikroorganismen, Zellen, Geweben oder kleinen Pflanzen, wie dem Laubmoos Physcomitrella patens.[1] Man unterscheidet zwischen flüssigen (zum Beispiel Bouillon, Nährbouillon oder Nährlösung) und gelierten („festen“) Nährmedien (Nährböden).
Anwendung

Flüssige Nährmedien
Flüssige Nährmedien werden eingesetzt
- für biotechnologische Produktionsverfahren (Bioreaktor)
- Zellkulturmedien zur Kultivierung von eukaryotischen Zellen (z. B. DMEM, MEM, RPMI-1640, Ham’s F-10 und Ham’s F-12) und Mikroorganismen (Mikroorganismenkultur) zu Forschungszwecken
- zur Kultivierung von lebenden Geweben für den medizinischen Einsatz (z. B. Hauttransplantationen)
- für den Nachweis oder zur Voranreicherung von Mikroorganismen (Anreicherungskultur)
- zur Prüfung auf bestimmte Stoffwechselleistungen von Mikroorganismen zu deren Identifizierung
- zur Quantifizierung von Mikroorganismen nach der Methode der „Wahrscheinlichsten Anzahl“ („Most Probable Number“, MPN-Verfahren).
Feste Nährmedien (Gelnährmedien)

Als Feste Nährmedien bezeichnet man Nährmedien, die durch Zusatz eines Geliermittels in Form eines Gels vorliegen. Feste Nährmedien werden vor allem zu Analysezwecken verwendet, denn sie ermöglichen auch eine Quantifizierung von Mikroorganismen: Da die Mikroorganismen sich nicht frei im Medium verteilen können, bilden sie bei ihrer Vermehrung um jeden auf oder im Nährmedium befindlichen Mikroorganismus eine sichtbare Kolonie. Die Anzahl dieser Kolonien entspräche also im Idealfall der ursprünglichen Anzahl von Mikroorganismen. Da jedoch eine Kolonie auch von mehreren dicht beieinander liegenden Individuen gebildet werden kann, entspricht die Anzahl der Kolonien nicht der tatsächlichen Anzahl der Mikroorganismen, sondern nur der Anzahl der Individuen und der in Gruppen im oder auf dem Nährboden verteilten Mikroorganismen. Diese Individuen und Individuengruppen bezeichnet man als KbE (Koloniebildende Einheit, auch cfu – colony forming units).[2]
Weiterhin werden feste Nährmedien verwendet, wenn die sich auf der Oberfläche des Nährmediumgels bildenden Kolonien mit charakteristischem Aussehen zur Charakterisierung und Identifizierung der Mikroorganismen herangezogen werden sollen.
Halbfeste Nährmedien
Halbfeste Nährmedien werden vor allem in hoher Schicht in Reagenzröhrchen, als „Hochschichtröhrchen“ bezeichnet, verwendet. Dieser sogenannte „Weichagar“ enthält Agar-Agar in geringerer Konzentration als bei einem festeren Nährmedium üblich. Mit ihm kann man bei vielen Mikroorganismen die durch Flagellen bewirkte aktive Bewegung (Motilität) nachweisen. Außerdem wird er zur Schaffung eines Sauerstoffgradienten verwendet, um mikroaerophile Organismen zu kultivieren, diese benötigen eine geringere Sauerstoffkonzentration als die, welche sich im Lösungsgleichgewicht mit der Luft einstellt.[2]
Zusammensetzung
Die Grundzusammensetzung eines Nährmediums besteht meist aus einem Hauptanteil Wasser, einer für den jeweiligen Organismus verwertbaren Energiequelle (siehe Chemotrophie), beispielsweise organische Verbindungen oder schwefelhaltige Verbindungen, sowie von ihm benötigte Nährstoffe (organische oder anorganische Kohlenstoff-, Stickstoff-, Schwefel- und Phosphat-Quellen sowie andere essentielle Nährstoffe). Die Nährstoffe werden auch Substrate genannt und sind in den Nährmedien für Heterotrophe meistens Kohlenhydrate („Zucker“, etwa Traubenzucker wie bei den Serumnährböden der Loeffler-Platte), Proteinhydrolysate (Peptone) und gegebenenfalls Fettsäuren. Zusätzlich liefern anorganische Salze dem Organismus lebenswichtige Ionen, wie z. B. Ammonium, Kalium, Natrium, Phosphat, Sulfat sowie Spurenelemente.[2]
Daneben können noch enthalten sein:[2]
- Farbstoffe bzw. deren Vorstufen (Mikroskopiefarbstoffe, chromogene Substrate)
- Geliermittel (Verfestigungsmittel), wie Agar-Agar oder (seltener) Gelatine,
- Hemmstoffe (zum Beispiel Antibiotika) und selektive Agentien, um das Wachstum unerwünschter Mikroorganismen zu verhindern (z. B. Chloramphenicol für Hefen/Schimmel-Nährböden)
- Indikatoren, um Änderungen anzuzeigen, wie z. B. beim pH-Wert, aber auch um gewisse Stoffwechselprodukte oder Stoffwechselaktivitäten anzuzeigen
- Puffersubstanzen, um den pH-Wert zu stabilisieren
- Wachstumsfaktoren (Suppline genannt), wie Hormone, Vitamine und dergleichen.
Zur Herstellung eines Nährmediums werden die Nähr- und Zusatzstoffe gemäß einer Rezeptur zusammengemischt und in destilliertem oder demineralisiertem Wasser (erforderlichenfalls unter Erhitzen mit heißem, strömendem Wasserdampf) gelöst. Anschließend erfolgt die Sterilisierung (meist durch Erhitzen im Autoklaven). Thermolabile Zusatzstoffe, die durch die Hitzesterilisierung zerstört würden, werden auf mechanischem Weg sterilisiert – meistens durch eine Sterilfiltration mit einem Membranfilter (Sterilfilter) – und dem Nährmedium erst nach dessen Hitzesterilisierung und Erkalten zugegeben.[3]
Feste Nährmedien enthalten mindestens 1 % Agar-Agar, je nach Rezeptur variiert die Konzentration zwischen 10 und 20 g Agar/l Nährmedium (Gramm pro Liter). Für einen sogenannten „Weichagar“ sind 1–4 g/l üblich. Historisch bedingt spricht man bei wässrigen Lösungen komplexer, organischer Substrate von Bouillon, da die ersten Nährmedien dieser Art noch in Anlehnung an Suppenrezepte hergestellt wurden. Solche Flüssigmedien ähneln in der Zusammensetzung den festen Nährmedien, nur ist bei ihnen kein Agar oder ein anderes Geliermittel enthalten.[2]
Einteilung
Kulturmedien lassen sich nach verschiedenen Gesichtspunkten einteilen:[2][3]
Nach Anwendungsgebiet
| Bezeichnung | Festmedium | Flüssigmedium |
|---|---|---|
| Enthält | meistens Agar als Geliermittel | kein Geliermittel |
| Anwendung | Bei Festmedien steht die Isolierung und Analyse der jeweiligen Mikroorganismen im Vordergrund, daher werden sie auch als Isolierungsmedien bezeichnet. Bei der Quantifizierung von Mikroorganismen verwendet man feste Medien zur Bestimmung der Koloniezahl. | Flüssigmedien werden als Anreicherungsmedium verwendet. Ebenso werden sie genutzt, wenn man größere Mengen einer Kultur benötigt. Bei der Quantifizierung von Mikroorganismen verwendet man flüssige Medien im Titerverfahren. |
Nach Inhaltsstoffen
.jpg)
| Bezeichnung | synthetisches Medium | komplexes Medium |
|---|---|---|
| Erklärung | Sie enthalten definierte Konzentrationen von chemisch exakt definierten Inhaltsstoffen. | Hier sind (auch) komplexe, organische Bestandteile enthalten, die chemisch nicht genau bestimmt sind. |
| enthält z. B. | D-Glucose, Ammoniumchlorid (NH4Cl), Magnesiumsulfat (MgSO4), Dikaliumhydrogenphosphat (K2HPO4) | Pepton, Caseinhydrolysat, Hefeextrakt, Fleischextrakt, Blut |
| Anwendung | Synthetische Medien dienen insbesondere zur Selektion bestimmter Arten von Mikroorganismen. Aber auch, wenn identische Anfangsbedingungen für Wiederholungsexperimente wichtig sind, werden sie eingesetzt. | Komplexe Medien (auch Komplettmedien genannt) werden am häufigsten verwendet und erlauben das Wachstum fast aller heterotropher Mikroorganismen. |
Nach Nährstoffansprüchen
| Bezeichnung | Minimalmedium | Vollmedium |
|---|---|---|
| Erklärung | Es enthält die absolut notwendigen Nährstoffe für das Wachstum des betreffenden Mikroorganismus („Existenzminimum“), diese sind chemisch definiert. | Es enthält darüber hinausgehende, wachstumsfördernde Stoffe und Suppline. |
| enthält z. B. | D-Glucose als Kohlenstoffquelle, Ammonium-Ionen als Stickstoffquelle, Sulfat-Ionen als Schwefelquelle | Pepton oder mehrere Aminosäuren als Stickstoffquelle, schwefelhaltige Aminosäuren als Schwefelquelle |
| Anwendung | Die Zusammensetzung eines Minimalmediums muss empirisch ermittelt werden oder bekannt sein, es dient also der Selektion und Beschreibung eines bestimmten Mikroorganismus. | Wegen der enthaltenen wachstumsfördernden Bestandteile ist ein Vollmedium zur Kultivierung zahlreicher Mikroorganismen geeignet. Ein komplexes Medium ist gleichzeitig ein Vollmedium. |
Nach Arbeitsaufwand

| Bezeichnung | Fertige Mischung | Fertigmedium |
|---|---|---|
| Erklärung | Bei häufig verwendeten Nährmedien werden die festen Bestandteile samt Geliermittel industriell zusammengestellt, um zu erreichen, dass die Zusammensetzung immer einheitlich gleich bleibt. Derartige Fertigmischungen liegen als Pulver, Granulat, Tabletten oder Lyophilisat vor. | Beim Fertigmedium ist das Medium bereits industriell hergestellt und in Petrischalen oder Röhrchen abgefüllt worden. |
| Anwendung | Diese vorgefertigten Mischungen müssen bei Bedarf nur noch in erhitztem Wasser gelöst und sterilisiert werden. | Das Fertigmedium kann ohne weitere Vorbereitung direkt eingesetzt werden. |
Nach Untersuchungsziel
Man verwendet Medien auch, um Mikroorganismen anhand bestimmter Eigenschaften zu selektieren. Dafür gibt es zwei Ansätze:[3]
Selektivmedien
Selektivmedien erlauben nur das Wachstum von bestimmten Mikroorganismen, die besondere Eigenschaften aufweisen, um sich in diesem Medium zu vermehren. Ein Beispiel sind Medien, die mit Antibiotika angereichert sind. In ihnen können nur solche Mikroorganismen wachsen, die gegen das verwendete Antibiotikum resistent sind.
Differentialmedien

Differentialmedien (auch Differenzierungsmedien oder Indikatornährböden genannt) erlauben das Wachstum von mehreren eingesetzten Mikroorganismen. Sie sind jedoch so zusammengesetzt, dass sich die entstehenden Kolonien der verschiedenen Mikroorganismen im Aussehen voneinander unterscheiden, so lassen sie sich differenzieren. Beispielsweise können auf Blutagar Bakterienstämme, die zur Hämolyse fähig sind, von anderen durch den Klärungshof um ihre Kolonien unterschieden werden (Eine klare Trennung verschiedener Bakterienarten auf Nährboden war 1876 Ferdinand Julius Cohn gelungen[4]).
Häufig enthalten Differentialmedien Farbstoffe oder pH-Indikatoren, mit denen man bestimmte Stoffwechselleistungen der Mikroorganismen sichtbar machen kann. Beispiele dafür sind der Abbau eines Kohlenhydrats durch Mikroorganismen unter Säurebildung, dabei wird der pH-Wert erniedrigt (sauer), oder der Abbau von Harnstoff oder Citrat durch Bakterien; dabei entstehen alkalische Abbauprodukte und der pH-Wert wird erhöht. Die Änderung des pH-Wertes wird mit Hilfe eines passenden pH-Indikators durch Farbumschlag angezeigt; dies führt zu einer Verfärbung des Mediums oder der Kolonien.
Ein bekanntes Medium, das beide dieser Prinzipien vereint, ist der MacConkey-Agar. Er enthält Gallensalze und Kristallviolett und verhindert dadurch das Wachstum von grampositiven Bakterien und wirkt so als Selektivmedium. Für seine Wirkung als Differentialmedium ist Lactose und Neutralrot enthalten, so dass Lactose-fermentierende Bakterien anhand eines Farbumschlages des pH-Indikators Neutralrot identifiziert werden können. Ein weiteres häufig verwendetes Kulturmedium, das sowohl als Selektivmedium wie auch als Differentialmedium wirkt, ist der XLD-Agar.
Replica Plating
Replica Plating (zu deutsch etwa Replikationsausplattierung) bezeichnet den Transfer aller Kolonien von einem festen Nährmedium zu einem anderen festen Nährmedium unter Erhalt der Anordnung der einzelnen Kolonien zueinander.[5] Auf einen Lederberg-Stempel wird hierzu ein steriles Samttuch gespannt, das zuerst auf eine mit Kolonien bewachsene Platte und anschließend auf eine unbewachsene Platte durch sanftes Aufdrücken übertragen wird. Durch den Abdruck entsteht eine Kopie der Kolonien auf dem festen Nährmedium, die zum Heranwachsen der Kolonien kultiviert wird. Die Florfasern des Samtes vermeiden ein Verschmieren der Kolonien. Vor der Verwendung von Samt wurde der Transfer von Kolonien mit sterilen Zahnstochern (nach E. Tatum) oder mit sterilem Filterpapier (nach N. Visconti) durchgeführt.
Weblinks
-
 Media Index for BAM (Liste von Nährmedien im Bacteriological Analytical Manual). In:
Website der U.S. Food and Drug Administration (FDA). 12. Oktober 2024, abgerufen am 20. November 2025.
Media Index for BAM (Liste von Nährmedien im Bacteriological Analytical Manual). In:
Website der U.S. Food and Drug Administration (FDA). 12. Oktober 2024, abgerufen am 20. November 2025.
Einzelnachweise
- ↑ Birgit Hadeler, Sirkka Scholz, Ralf Reski (1995) Gelrite and agar differently influence cytokinin-sensitivity of a moss. Journal of Plant Physiology 146, 369–371.
- ↑ Hochspringen nach: a b c d e f Eckhard Bast: Mikrobiologische Methoden: Eine Einführung in grundlegende Arbeitstechniken. 2. Auflage. Spektrum Akademischer Verlag GmbH, Heidelberg/Berlin 2001, ISBN 978-3-8274-1072-6.
- ↑ Hochspringen nach: a b c Roland Süßmuth, Jürgen Eberspächer, Rainer Haag, Wolfgang Springer: Biochemisch-mikrobiologisches Praktikum. 1. Auflage. Thieme Verlag, Stuttgart/New York 1987, ISBN 3-13-685901-4, S. 12–15.
- ↑ Paul Diepgen, Heinz Goerke: Aschoff: Kurze Übersichtstabelle zur Geschichte der Medizin. 7., neubearbeitete Auflage. Springer, Berlin/Göttingen/Heidelberg 1960, S. 42.
- ↑ J. Lederberg, E. M. Lederberg: Replica plating and indirect selection of bacterial mutants. In: J Bacteriol. (1952), Band 63(3), S. 399–406.
 PMID 14927572;
PMID 14927572;
 PMC 169282 (freier Volltext).
PMC 169282 (freier Volltext).


© biancahoegel.de
Datum der letzten Änderung: Jena, den: 20.11. 2025